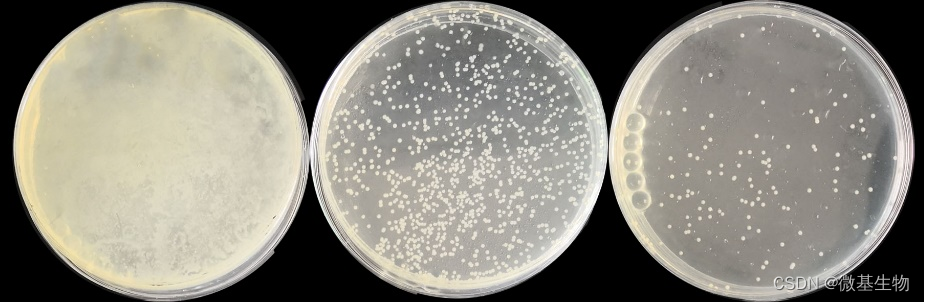
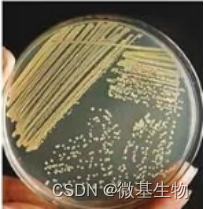

微基生物微生物分离培养项目主要采用下面的流程:

实验流程和目的
步骤一、原始样本微生态检测:
在进行分离培养前,需要首先确认待分离的样本中是否有目标菌株,这时需要通过高通量测序的方法来检测样本中微生物的种类和相对丰度。
如果希望分离细菌,那么可以选择16S V3-V4或是16S V4-V5区域对原始样本进行测序。如果希望分离真菌,那么可以选择ITS序列进行测序。
步骤二、确认目标菌株:
通过高通量检测原始样本中微生物的种类和相对丰度,确定后续要进行分离纯化的目标菌株。若样本中可以检测到目标菌株,则该样本可以进行后续的实验。若原始样本中没有目标菌株,则建议更换样本。
如果测序结果中没有指定的菌株,但是已知该菌株的16S序列,我们也可以分析测序结果中有没有和目标16S序列一致的OTU(或是ASV)代表序列。这样分析,主要是考虑到高通量测序结果中有些微生物无法鉴定到具体的种,这时我们可以根据16S的序列来判断目标菌株在原始样本中的相对丰度。
步骤三、培养条件筛选:
根据目标菌株查找相关的培养信息(这个步骤尽量多采用几种培养方法),将不同的培养基分别配置成固体平板,将样本进行梯度稀释(如下图1所示)。

图1 梯度稀释的方法
取部分菌液均匀涂布到不同的培养基表面上,按照指定的培养条件进行需氧或厌氧培养,稀释倍数低的样本会在平板上长成菌苔,而稀释倍数高的样本则会形成单菌落。例如下图2所示,从左至右样本的稀释倍数分别为10倍(菌苔)、100倍(菌落)和1000倍(菌落)。
图2 梯度稀释涂布平板培养后的菌苔和菌落
每种培养基挑选一个长成菌苔的平板和一个长出菌落的平板(如上图的第1板和第2板),收集菌体并取部分进行16S/ITS高通量测序,剩余菌体加保护剂冻存。通过生物信息学分析培养出来的微生物种类和相对丰度,判断在哪种培养基上能够较好地富集目标微生物。
若在一种培养基的菌苔和菌落中目标菌株的相对丰度都很低,则表明该菌株不适合用此种方法培养,需要更换其他的培养条件。若目标菌株在菌落平板上有培养出来,且相对丰度较高,则表明该菌株比较容易在此培养基上培养出来,可以用这种培养方法做后续的分离和纯化。若目标菌株在菌苔样品中的相对丰度较高,而在菌落样品中的相对丰度较低,则表明此菌株可能和其他菌株之间存在共生关系,此时需要考虑使用共培养的方法或使用共生菌的替代物对目标菌株进行分离纯化。
步骤四、目标菌株分离:
根据菌苔和菌落的16S/ITS高通量结果,选择最适合目标菌株的培养方法,按照步骤三的方法,将原始样本稀释后进行涂板培养,挑选平板上的单克隆于96孔板中进行液体培养基摇菌培养。取扩培后的菌液进行菌种保存,同时进行16S/ITS高通量测序,根据测序结果初步筛选出目标菌株。
步骤五、目标菌株纯化:
初筛得到的菌株中可能还存在杂菌,因此需要对菌株进一步纯化。取少量菌体在培养基平板上作四区划线纯化(如图3所示),根据目标菌株的纯度,纯化2-3代,并进行一代或是二代测序验证,最终获得纯菌株。
图3 四区划线
备注:
有限梯度稀释培养:对于不适合在固体培养基平板上生长的菌株,可以采用有限梯度稀释法在液体培养基中进行分离纯化。
名词注释:
1、厌氧培养、需氧培养:
厌氧培养(anaerobic culture)指把微生物置于与分子态氧隔绝状态下(一般是在厌氧手套箱中)进行的培养,适用于兼性厌氧菌和专性厌氧菌。培养时所使用的气体可以按需求调整,常用气体的有纯N2和85% H2-10% CO2-5% H2混合气体等。
需氧培养(aerobic culture)与厌氧培养相对的,微生物直接在空气条件下进行培养,适用于需氧菌和部分兼性厌氧菌。
2、厌氧手套箱:
厌氧手套箱(anaerobie glove box)是迄今为止国际上公认的培养厌氧菌最佳仪器之一。它是一个密闭的大型金属箱,箱子的前面有一个有机玻璃做的透明面板,板上装有两个手套,可通过手套在箱内进行操作。每次样品进入箱内时,都需要经过反复抽真空和充氮的过程,确保操作室内维持无氧的环境。

3、梯度稀释和取样涂板:
梯度稀释就是依次稀释样本,比如取1mL原液加入9mL稀释液中稀释10倍,混匀后,再从这里面取1mL与下一管9mL稀释液混和,依次类推,称为梯度稀释。

4、菌落(colony)/单克隆(clone):
指由单个细胞在适宜的固体培养基表面或内部生长繁殖到一定程度,形成以母细胞为中心的一团肉眼可见的、有一定形态和构造等特征的子细胞集团。每一种细菌在一定条件下形成的菌落特征是固定的,而不同种或同种在不同的培养条件下形成的菌落特征是不同的。这些特征对菌种识别和鉴定有一定意义。
5、菌苔(lawn):
与菌落的概念不同,如果是许多细菌菌体接种在固体培养基上,经培养后长成密集的、不规则的片状的细胞群体,则称为菌苔。
6、平板划线纯化:








 本文详细介绍了微生物分离培养的流程,包括原始样本微生态检测、目标菌株确认、培养条件筛选、目标菌株分离及纯化。通过高通量测序方法检测样本微生物种类,依据目标菌株特性选择合适的培养基和培养条件,最终实现目标菌株的纯化。该过程涉及梯度稀释、平板划线、菌落和菌苔分析等关键技术。
本文详细介绍了微生物分离培养的流程,包括原始样本微生态检测、目标菌株确认、培养条件筛选、目标菌株分离及纯化。通过高通量测序方法检测样本微生物种类,依据目标菌株特性选择合适的培养基和培养条件,最终实现目标菌株的纯化。该过程涉及梯度稀释、平板划线、菌落和菌苔分析等关键技术。
 最低0.47元/天 解锁文章
最低0.47元/天 解锁文章


















 1万+
1万+

 被折叠的 条评论
为什么被折叠?
被折叠的 条评论
为什么被折叠?








